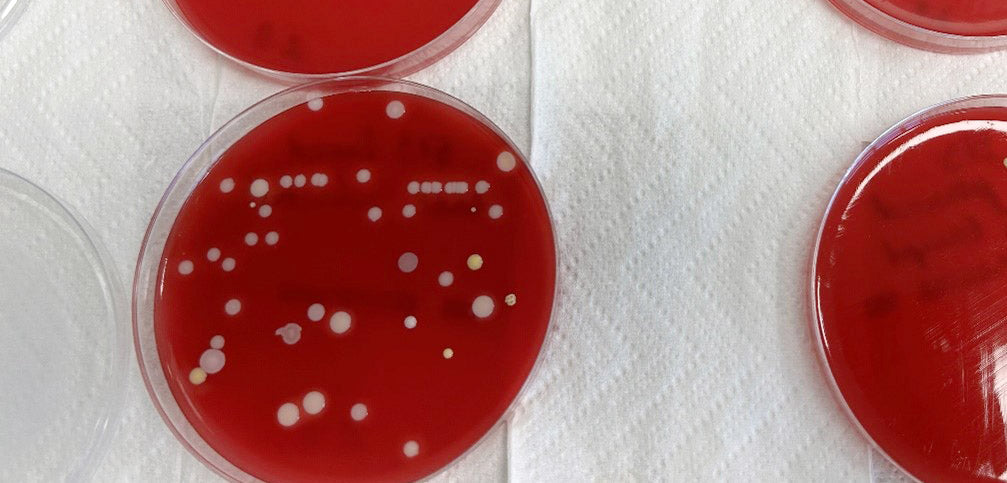

Why Chemical Disinfection Doesn't Always Meet Expectations
Share
Synlab, a world-leading clinical service laboratory, recently compared Spectral Blue with one of their regular chemical disinfectants in real-life conditions.
The test results showed that, contrary to most people's expectations, substantial contamination can be found on laboratory workbenches even after they have been disinfected with a chemical.
After they tested Spectral Blue multi-wavelength blue light on the same workbenches the contamination was practically gone.
Test setup:
Step 1: Two laboratory workbenches and equipment placed on them were first cleaned with chemical disinfection agents just before sampling.
Step 2: Microbial surface samples (swabs) were taken from the tabletops and the equipment. The samples were applied on BD Columbia Agar petri dishes (5% sheep blood) and incubated for 48 hours at 37 degrees Celsius.
Step 3: The same workbenches and equipment were illuminated with a Spectral Blue device overnight.
Step 4: In the morning (after approximately 12 hours), similar microbial surface samples were taken from same locations and cultivated in the same way as in step 2.
Results:
In visual inspection, the cultured plates from step 2 (chemical disinfection only) showed much higher number of microbial colonies than those from step 4 (chemical disinfection and Spectral Blue illumination).

We are used to seeing perfect 4-log disinfection results for various chemical disinfectants. There is no question that the chemicals used by professional organizations wouldn't work as advertised - they do. But the key to reading the stated test results is that they have been achieved in perfect laboratory conditions.
In real life use, it is not easy for the human operator to spread the chemical uniformly on the surfaces. In all likelihood, there will be some areas with better coverage and some areas with worse coverage - or no coverage at all.
Also the contact times required by a chemical disinfectant to work typically range from 5 minutes to 30 minutes. Keeping the surfaces moist for the required duration cannot be guaranteed in practical situations.
The chemical disinfection process cannot work if full coverage is not achieved and contact times cannot be obeyed.
- A further consideration with chemical disinfectants are the residues left on surfaces. The chemical residues can act as a growth platform for microbes and lead to the forming of so called dry biofilm. Any residues should therefore be removed by wiping with a microfiber cloth, using a neutral detergent and water. Based on our experience, this task is often overlooked.
For these reasons, chemical disinfection most likely does not meet expectations in real-life use.
Having your organization's hygiene processes depend on such hit or miss methods is a substantial risk. Many organizations are now finding out.
Conclusion:
This quick test shows that chemical disinfection does not always perform as expected in real-life conditions. Organizations relying solely on chemicals are at risk of expensive hygiene failures.
Automated Spectral Blue disinfection, on the other hand, delivers the same great results every day. It delivers high consistency and high quality without user input.
For decision makers the conclusion is clear - automation is the right path forward also in disinfection. And reducing our dependency on hazardous and unsustainable chemicals is a worthy goal in itself.
Wish to learn more about what Spectral Blue can do to improve your process quality? Contact us to talk with an expert.
Related articles: